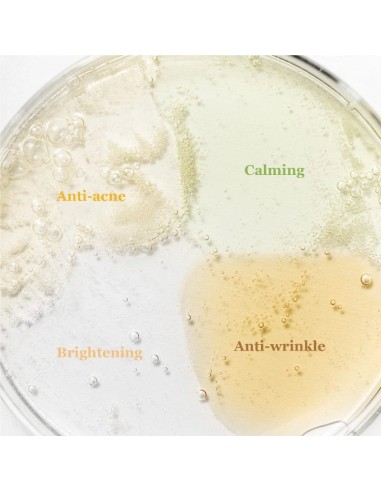
BEAUTY OF JOSEON Hanbang Serum Discovery Kit - Kit 4 Sérums

Beauty of Joseon es una marca de clean beauty conocida por sus productos para el cuidado de la piel arraigados en el Hanbang.
Se conoce como Hanbang a la Medicina Tradicional Coreana, un enfoque holístico de la salud que busca la armonía entre la mente y el cuerpo. El concepto Hangbang aplicado a la cosmética fusiona ingredientes naturales y extractos de hierbas de la medicina ancestral coreana, con tecnologías vanguardistas de última generación. Consigue una piel sana y radiante, conectando pasado y presente.
Una firma de belleza de culto, que puede presumir de ser la creadora de algunos de los productos de cosmética coreana más vendidos. No te pierdas la crema hidratante para piel seca, Dynasty Cream, o la crema solar con factor de protección SPF50, Relief Cream.
Realza la belleza natural y da respuesta a las necesidades esenciales de la piel. Aborda preocupaciones básicas como la sequedad, la producción excesiva de grasa cutánea, o la apariencia irregular y el tono desigual de la piel.
La marca se apoya en la convicción de que el cuidado de la piel trasciende las tendencias y no necesita adherirse a nociones de lujo. Su sello de calidad, atemporal, son los ingredientes y sus fórmulas limpias, cruelty free y aptas para uso vegano.
El Kit de Descubrimiento de Hanbang es para ti...
Si quieres descubrir los populares sérums de la marca Beauty of Joseon y encontrar el que mejor se ajuste a las necesidades de tu tipo de piel
Si buscas un sérum en formato mini o tamaño de viaje
Si te gustaría poder disfrutar de un tatamiento de belleza tipo layering, allá donde vayas
¿QUÉ INCLUYE ESTE KIT DE VIAJE?
1. Calming Serum : Green Tea + Panthenol
La fórmula contiene agua de hoja de té verde 76% + Pantenol 2%
Ingredientes clave: extracto de centella asiática, extracto de artemisia y hialuronato de sodio
Textura acuosa, ligera y de absorción rápida
Beneficios: calma la piel sensible o irritada
2. Glow Serum : Propolis + Niacinamide
La fórmula contiene extracto de Propóleo 60% + Niacinamida 2%
Ingredientes clave: betaína (BHA), aceite de tamaru y árbol de té
Textura similar a la miel.
Beneficios: ilumina el rostro y tiene propiedades antiinflamatorias
3. Glow Deep Serum : Rice + Alpha-Arbutin
La fórmula contiene Salvado de Arroz 68% + Alfa-Arbutina 2%
Ingredientes clave: Glicerina, Niacinamida, Semilla de Soja, Cebada, Extracto de Arroz y Sésamo
Textura acuosa y ligera
Beneficios: mejora la luminosidad de la piel y tiene propiedades despigmentantes
4. Revive Serum : Ginseng + Snail Mucin
La fórmula contiene Agua de Raíz de Ginseng 63% + Mucina de Caracol 3%
Ingredientes clave: Extracto de Raíz de Ginseng, Adenosina y Extracto de Matsutake
Textura similar a la mucina
Beneficios: suaviza la textura de las arrugas y aporta luminosidad a la piel.
INFORMACIÓN RSGP
Responsable en Europa del producto y dirección: Cosibella Sp. z o. o. Dirección: ul. Jutrzenki 177, 02-231 Varsovia, REGON 385746050, NIP 5223180504
E-mail del responsable: zamowienia@cosibella.pl
Página Web del Responsable: https://cosibella.pl/
Precauciones PIF: Producto para uso externo únicamente. No utilizar sobre piel dañada. Si aparece cualquier signo de irritación, suspenda el uso del producto. Mantener fuera del alcance de los niños. Conservar el producto a temperatura ambiente, en un lugar sombreado. Las fluctuaciones de temperatura durante el transporte no afectarán la estabilidad ni las propiedades del producto.
Beauty of Joseon es una marca cruelty free, libre de aceites esenciales, ingredientes químicos y fragancias artificiales.
 Preferencias sobre cookies
Preferencias sobre cookies